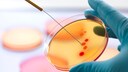
antibiotikaresistenz: Wissenschaftler bei einer Laboruntersuchung

14. April 2025, 13:46 Uhr | Lesezeit: 5 Minuten
Eine häufige und lange Einnahme von Antibiotika kann zu einer Resistenz führen, was lebensbedrohliche Folgen haben kann, so auch bei Kindern. Das unterstreicht eine Studie, welche die Zahl an Todesfällen bei Kindern durch Medikamentenresistenz analysierte – und kam zu einer erschreckend hohen Quote.
Durch jede Antibiotika-Einnahme fördert man die Bildung von Resistenzen, denn obwohl empfindliche Bakterien abgetötet werden, überleben die resistenten und vermehren sich. Wenn man erstmal nicht mehr auf eine Behandlung mit Antibiotikum anspricht, kann es gefährlich werden, da sich manche Erkrankungen schwieriger behandeln lassen.1 Auch Kinder sind davon betroffen, eine Antibiotikaresistenz kann sogar tödliche Folgen annehmen. Das verdeutlichte eine Studie aus dem Jahr 2023, welche auf dem ESCMID Global 2025 erneut vorgestellt wurde.
Jetzt dem FITBOOK-Kanal bei Whatsapp folgen!
Übersicht
Forschung zu Resistenzen bei Kindern bislang lückenhaft
Antimikrobielle Resistenzen (AMR) stellen eine der größten globalen Gesundheitsgefahren dar – besonders für Kinder, die aufgrund ihres noch nicht ausgereiften Immunsystems anfälliger für Infektionen sind. Dennoch ist die Forschung zu antimikrobiellen Resistenzen bei Kindern bislang lückenhaft. Die vorliegende Studie hatte daher das Ziel, diese Wissenslücke zu schließen und systematisch die weltweiten Trends und Muster von Antibiotikaresistenzen bei Kindern zu erfassen.
Auch interessant: Bis 2050 sollen 39 Millionen Todesfälle auf Antibiotikaresistenzen zurückzuführen sein
Analyse von mehr als 100.000 Daten von Kindern
Die Forscher führten eine retrospektive Datenauswertung mithilfe der Vivli-Plattform durch – einer internationalen Datenbank klinischer Studiendaten.2 Grundlage der Analyse waren 858.233 bakterielle Isolate aus 83 Ländern in einem Zeitraum von 18 Jahren, darunter 101.661 von Kindern. Die Einteilung der Antibiotika erfolgte nach dem WHO-AWaRe-System:
- „Access“-Antibiotika sind erstzugängliche Mittel mit geringem Resistenzpotenzial
- „Watch“-Antibiotika haben ein höheres Resistenzrisiko
- „Reserve“-Antibiotika gelten als letzte Behandlungsoption bei multiresistenten Infektionen.
Mithilfe wissenschaftlicher statistischer Verfahren wertete man anschließend die Daten aus. Ziel war es, globale und regionale Entwicklungen sichtbar zu machen, genetische Resistenzen zu identifizieren und potenzielle zukünftige Szenarien zu modellieren. Damit liefert die Studie eine entscheidende Grundlage für zielgerichtete Strategien zur Eindämmung antimikrobieller Resistenzen im Kindesalter.
Drastischer Anstieg von Antibiotikaresistenzen bei Kindern
Die Analyse von über 100.000 Kinder-Isolaten ergab beunruhigende Trends: Besonders bei gramnegativen Bakterien wie Klebsiella pneumoniae, Escherichia coli, Enterobacter cloacae und Acinetobacter baumannii wurden steigende Resistenzen gegen „Watch“- und „Reserve“-Antibiotika festgestellt. Und auch bei Cephalosporinen nahmen die Resistenzen zu.
Regional zeigten sich besonders hohe Resistenzraten in Ländern mit niedrigen und mittleren Einkommen, obwohl aus diesen Regionen vergleichsweise weniger Daten vorlagen. Prognosen zufolge könnten die Resistenzen gegen „Watch“-Antibiotika bei den genannten Erregern in den nächsten zehn Jahren um über 50 Prozent steigen, bei „Reserve“-Antibiotika sogar um mehr als 25 Prozent – sofern keine Gegenmaßnahmen ergriffen werden.
Welche Bedeutung haben die Ergebnisse?
Die Studie verdeutlicht die zunehmende Bedrohung durch antibiotikaresistente Infektionen bei Kindern – mit bereits heute dramatischen Folgen: Im Jahr 2022 starben über 3 Millionen Kinder weltweit an antimikrobiellen, Resistenzen-bedingten Komplikationen, davon allein 752.000 in Südostasien und 659.000 in Afrika. Besonders brisant ist der massive Anstieg des Einsatzes von „Watch“-Antibiotika:
- Zunahme um 160 Prozent in Südostasien
- Zunahme um 126 Prozent in Afrika
Auch bei den „Reserve“-Antibiotika beobachtete man einen drastischen Anstieg:
- Zunahme um 45 Prozent in Südostasien
- Zunahme um 125 Prozent in Afrika
Diese Reservemittel sind eigentlich nur für schwerste, multiresistente Infektionen vorgesehen. Ihre übermäßige Nutzung fördert jedoch die Ausbildung resistenter Erreger und reduziert langfristig die Wirksamkeit lebenswichtiger Medikamente. Besonders in einkommensschwachen Regionen wirken sich strukturelle Probleme wie überfüllte Kliniken, mangelhafte Hygiene und fehlende Überwachungssysteme verstärkend aus.
„Der vermehrte Einsatz von Watch-and-Reserve-Antibiotika mag zwar angesichts der gleichzeitigen Zunahme medikamentenresistenter Infektionen notwendig sein, doch birgt der starke Anstieg dieser Medikamente auch schwerwiegende Langzeitrisiken. Ihr vermehrter Einsatz, insbesondere ohne sorgfältige Überwachung, erhöht das Resistenzrisiko und schränkt zukünftige Behandlungsmöglichkeiten ein. Sollten Bakterien Resistenzen gegen diese Antibiotika entwickeln, gibt es kaum noch Alternativen zur Behandlung multiresistenter Infektionen“, betont Professor Joseph Harwell, Co-Autor der Studie, die Gefahr.3 „Die bereits jetzt alarmierend hohen Sterblichkeitsraten werden weiter deutlich steigen, insbesondere in Ländern mit niedrigem und mittlerem Einkommen, wo der Zugang zu alternativen Behandlungen und fortschrittlichen medizinischen Eingriffen möglicherweise eingeschränkt ist.“
Einordnung der Studie und mögliche Einschränkungen
„Auf regionaler Ebene fordern wir die politischen Entscheidungsträger auf, krankenhausbasierte Antibiotika-Management-Programme in allen pädiatrischen Gesundheitseinrichtungen vorzuschreiben. Verbesserte Altersklassifizierungen in den Überwachungsdaten werden zudem unser Verständnis wichtiger Unterschiede in den Resistenzraten zwischen den Altersgruppen sowie pädiatrischer Resistenzmechanismen verbessern. Darüber hinaus drängen wir auf die Umsetzung nationaler Richtlinien, um sicherzustellen, dass die routinemäßige Überwachung den Antibiotika-Einsatz beeinflusst“, so Professor Harwell abschließend. Er macht deutlich, dass die Studie aufgrund ihrer Datengröße und langen Laufzeit von 18 Jahren eine hohe Aussagekraft besitzt.
Allerdings gibt es auch Einschränkungen: Die Datenlage aus Ländern mit niedrigem Einkommen war lückenhaft, was regionale Vergleiche erschwert. Zudem handelt es sich um eine Beobachtungsstudie – kausale Zusammenhänge können daraus nicht abgeleitet werden. Die Erfassung von Isolaten erfolgte teils heterogen, und nicht alle Länder verfügten über nationale Surveillance-Programme. Trotz dieser Einschränkungen liefert die Studie entscheidende Impulse für eine Neuausrichtung der globalen Resistenz-Strategie im Kindesalter.
Jährlich 35.000 Todesfälle durch Antibiotikaresistenzen

Bis 2050 sollen 39 Millionen Todesfälle auf Antibiotikaresistenzen zurückzuführen sein

Die jährlichen Brustkrebs-Todesfälle sollen bis 2050 um 68 Prozent steigen
Fazit
Diese Studie zeigt mit Nachdruck, dass Antibiotikaresistenzen bei Kindern eine akute globale Gesundheitskrise darstellen – insbesondere in ärmeren Regionen. Die Zunahme multiresistenter Erreger und die Übernutzung kritischer Reserveantibiotika erfordern rasches, international abgestimmtes Handeln. Dazu gehören flächendeckende Überwachungssysteme, verpflichtende Antibiotika-Programme in Kinderkliniken und eine altersgerechte Datenerhebung. Nur durch konsequente Maßnahmen kann verhindert werden, dass resistenzbedingte Todesfälle bei Kindern weiter steigen – und die Wirksamkeit lebensrettender Medikamente dauerhaft verloren geht.